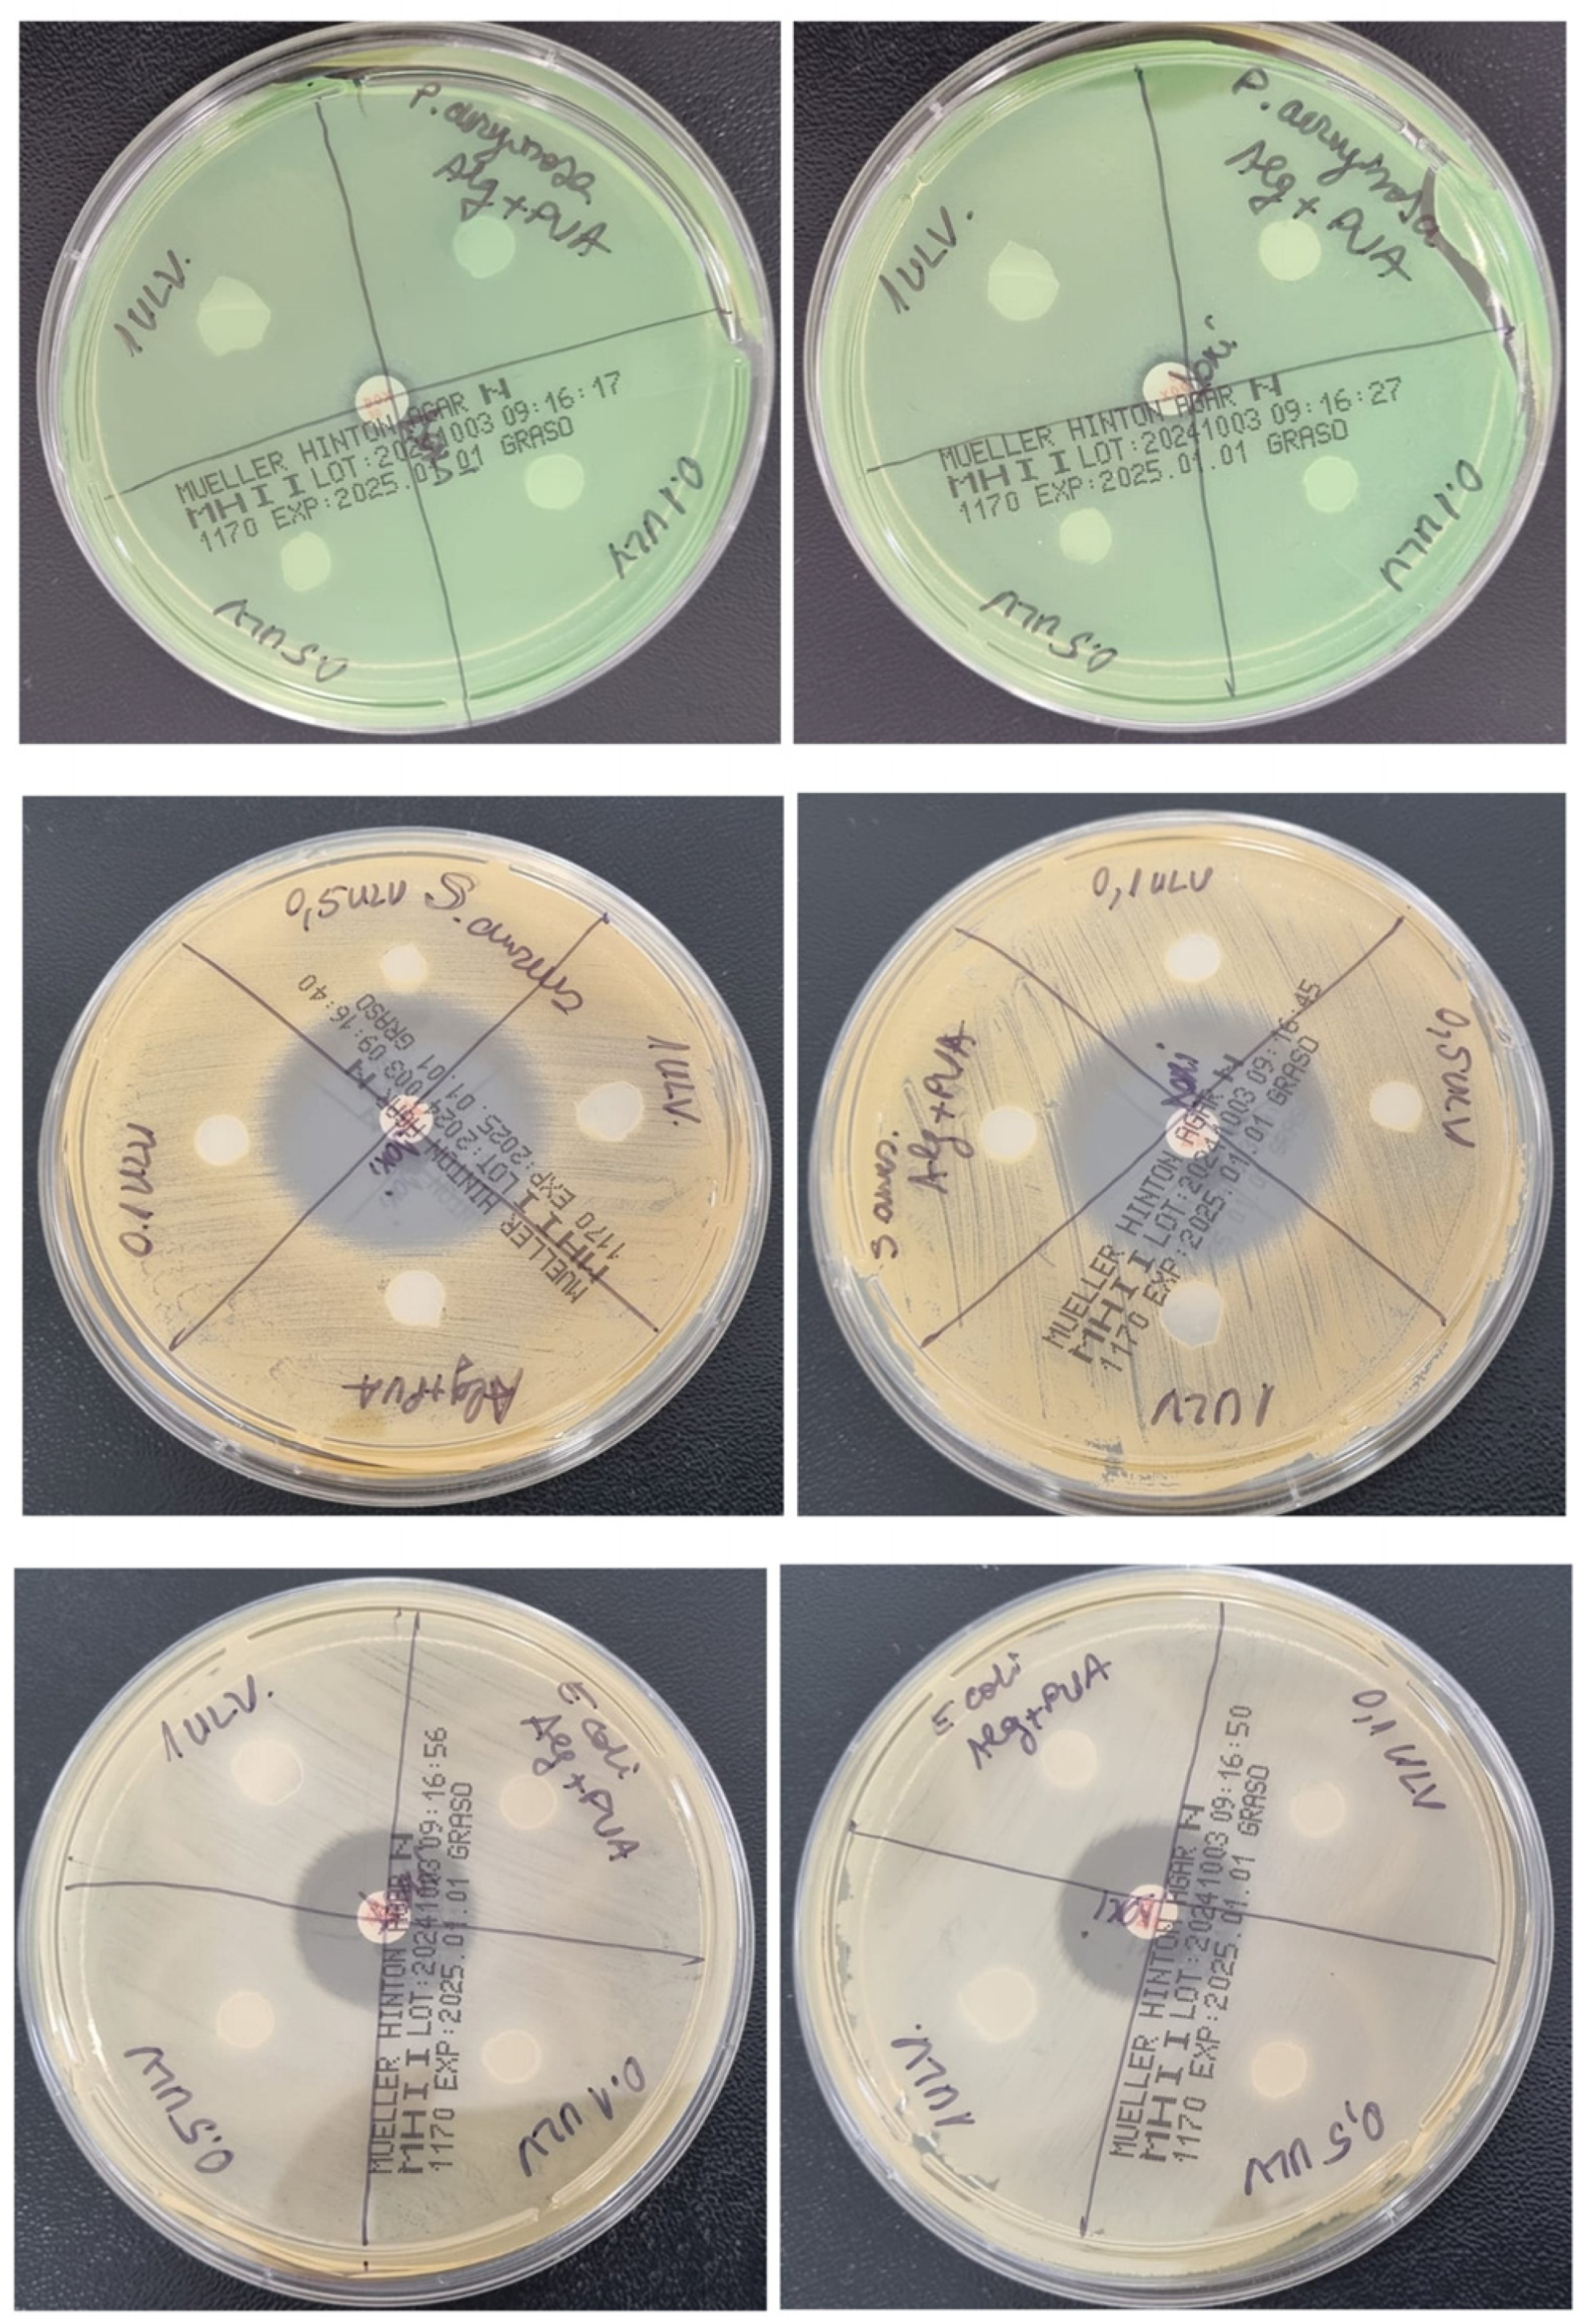
Gels 11 00017 g014

Hybrid Hydrogel Supplemented with Algal Polysaccharide for Potential Use in Biomedical Applications
Abstract
1. Introduction
2. Results and Discussion
2.1. Ulvan Extraction and Characterization
2.2. Physical and Mechanical Properties of the Hydrogel Membranes
2.2.1. Variation of pH
2.2.2. Swelling Index
2.2.3. Gel Fraction
2.2.4. Moisture Content and Uptake
2.2.5. Protein Adsorption
2.2.6. Inhibition of Protein Denaturation
2.2.7. Hydrolytic Degradation
2.3. Mechanical and Morphological Properties of the Hydrogel Membranes
2.3.1. Rheological Studies
2.3.2. SEM Analysis
2.4. Antimicrobial Analysis
2.5. Cytotoxicity Evaluation
2.6. Scratch Wound Evaluation
3. Conclusions
4. Materials and Methods
4.1. Materials
4.2. Ulvan Extraction and Characterization
4.2.1. NMR Analysis
4.2.2. FTIR Analysis
4.2.3. Elemental Analysis
4.2.4. GC-MS Analysis
4.2.5. Acid Methanolysis of Ulvan
4.3. Hydrogel Membrane Synthesis
4.4. Hydrogel Membrane Physico-Chemical Characterization
4.4.1. pH Variation Analysis
4.4.2. Swelling Index
4.4.3. Gel Fraction
4.4.4. Moisture Content
4.4.5. Moisture Uptake
4.4.6. Protein Adsorption
4.4.7. Inhibition of Protein Denaturation
4.4.8. Hydrolytic Degradation
4.5. Hydrogel Membrane Morphological and Mechanical Characterization
4.5.1. SEM Analysis
4.5.2. Rheological Studies
4.6. Antibacterial Effect Evaluation
4.7. In Vitro Cytotoxicity Tests
4.8. Scratch Wound Assay
Author Contributions
Funding
Institutional Review Board Statement
Informed Consent Statement
Data Availability Statement
Acknowledgments
Conflicts of Interest
References
- Yang, C.; Yang, C.; Chen, Y.; Liu, J.; Liu, Z.; Chen, H.-J. The trends in wound management: Sensing, therapeutic treatment, and “theranostics”. J. Sci. Adv. Mater. Devices 2023, 8, 100619. [Google Scholar] [CrossRef]
- Sen, C.K. Human Wound and Its Burden: Updated 2022 Compendium of Estimates. Adv. Wound Care 2023, 12, 657–670. [Google Scholar] [CrossRef]
- Lindholm, C.; Searle, R. Wound management for the 21st century: Combining effectiveness and efficiency. Int. Wound J. 2016, 13, 5–15. [Google Scholar] [CrossRef]
- Nguyen, H.M.; Ngoc Le, T.T.; Nguyen, A.T.; Thien Le, H.N.; Pham, T.T. Biomedical materials for wound dressing: Recent advances and applications. RSC Adv. 2023, 13, 5509–5528. [Google Scholar] [CrossRef] [PubMed]
- Jin, S.G. Production and Application of Biomaterials Based on Polyvinyl alcohol (PVA) as Wound Dressing. Chem. Asian J. 2022, 17, e202200595. [Google Scholar] [CrossRef] [PubMed]
- Mariello, M.; Binetti, E.; Todaro, M.T.; Qualtieri, A.; Brunetti, V.; Siciliano, P.; De Vittorio, M.; Blasi, L. Eco-Friendly Production of Polyvinyl Alcohol/Carboxymethyl Cellulose Wound Healing Dressing Containing Sericin. Gels 2024, 10, 412. [Google Scholar] [CrossRef]
- Oliveira, R.N.; Meleiro, L.A.d.C.; Quilty, B.; McGuinness, G.B. Release of natural extracts from PVA and PVA-CMC hydrogel wound dressings: A power law swelling/delivery. Front. Bioeng. Biotechnol. 2024, 12, 1406336. [Google Scholar] [CrossRef]
- Chopra, H.; Bibi, S.; Kumar, S.; Khan, M.S.; Kumar, P.; Singh, I. Preparation and Evaluation of Chitosan/PVA Based Hydrogel Films Loaded with Honey for Wound Healing Application. Gels 2022, 8, 111. [Google Scholar] [CrossRef] [PubMed]
- Song, S.; Liu, Z.; Abubaker, M.A.; Ding, L.; Zhang, J.; Yang, S.; Fan, Z. Antibacterial polyvinyl alcohol/bacterial cellulose/nano-silver hydrogels that effectively promote wound healing. Mater. Sci. Eng. C 2021, 126, 112171. [Google Scholar] [CrossRef] [PubMed]
- Zhang, Q.; Zhang, M.; Wang, T.; Chen, X.; Li, Q.; Zhao, X. Preparation of aloe polysaccharide/honey/PVA composite hydrogel: Antibacterial activity and promoting wound healing. Int. J. Biol. Macromol. 2022, 211, 249–258. [Google Scholar] [CrossRef] [PubMed]
- Golafshan, N.; Rezahasani, R.; Tarkesh Esfahani, M.; Kharaziha, M.; Khorasani, S.N. Nanohybrid hydrogels of laponite: PVA-Alginate as a potential wound healing material. Carbohydr. Polym. 2017, 176, 392–401. [Google Scholar] [CrossRef] [PubMed]
- Lin, J.; Jiao, G.; Kermanshahi-Pour, A. Algal Polysaccharides-Based Hydrogels: Extraction, Synthesis, Characterization, and Applications. Mar. Drugs 2022, 20, 306. [Google Scholar] [CrossRef] [PubMed]
- Winter, R. Chronic Wounds and Their Therapy with Alginate-Based Dressings. J. Pers. Med. 2022, 12, 1356. [Google Scholar] [CrossRef] [PubMed]
- Rasyida, A.; Halimah, S.; Wijayanti, I.D.; Wicaksono, S.T.; Nurdiansah, H.; Silaen, Y.M.T.; Ni’mah, Y.L.; Ardhyananta, H.; Purniawan, A. A Composite of Hydrogel Alginate/PVA/r-GO for Scaffold Applications with Enhanced Degradation and Biocompatibility Properties. Polymers 2023, 15, 534. [Google Scholar] [CrossRef] [PubMed]
- Ghazagh, P.; Frounchi, M. Hydroxyapatite/alginate/polyvinyl alcohol/agar composite double-network hydrogels as injectable drug delivery microspheres. Chem. Pap. 2024, 78, 2967–2976. [Google Scholar] [CrossRef]
- Cho, S.H.; Lim, S.M.; Han, D.K.; Yuk, S.H.; Im, G.I.; Lee, J.H. Time-dependent alginate/polyvinyl alcohol hydrogels as injectable cell carriers. Journal of biomaterials science. Polym. Ed. 2009, 20, 863–876. [Google Scholar] [CrossRef]
- Bahadoran, M.; Shamloo, A.; Nokoorani, Y.D. Development of a polyvinyl alcohol/sodium alginate hydrogel-based scaffold incorporating bFGF-encapsulated microspheres for accelerated wound healing. Sci. Rep. 2020, 10, 7342. [Google Scholar] [CrossRef]
- Pinto, C.; Méndez, L.; Camacho-Rodríguez, B.; Silva-Cote, I. Antibacterial PVA/Chitosan/alginate/Meropenem-based hydrogel as a potential therapeutic strategy for chronic ulcers infections. Int. J. Polym. Mater. Polym. Biomater. 2023, 73, 1021–1033. [Google Scholar] [CrossRef]
- Li, C.; Tang, T.; Du, Y.; Jiang, L.; Yao, Z.; Ning, L.; Zhu, B. Ulvan and Ulva oligosaccharides: A systematic review of structure, preparation, biological activities and applications. Bioresour. Bioprocess. 2023, 10, 66. [Google Scholar] [CrossRef] [PubMed]
- Kidgell, J.T.; Magnusson, M.; de Nys, R.; Glasson, C.R.K. Ulvan: A systematic review of extraction, composition and function. Algal Res. 2019, 39, 101422. [Google Scholar] [CrossRef]
- Sulastri, E.; Lesmana, R.; Zubair, M.S.; Elamin, K.M.; Wathoni, N. A Comprehensive Review on Ulvan Based Hydrogel and Its Biomedical Applications. Chem. Pharm. Bull. 2021, 69, 432–443. [Google Scholar] [CrossRef] [PubMed]
- Rajinikanth, B.S.; Rajkumar, D.S.R.; Keerthika, K.; Vijayaragavan, V. Chitosan-Based Biomaterial in Wound Healing: A Review. Cureus 2024, 16, e55193. [Google Scholar] [CrossRef] [PubMed]
- Ahmadi, F.; Oveisi, Z.; Samani, S.M.; Amoozgar, Z. Chitosan based hydrogels: Characteristics and pharmaceutical applications. Res. Pharm. Sci. 2015, 10, 1–16. [Google Scholar] [PubMed]
- de Sousa Victor, R.; Marcelo da Cunha Santos, A.; Viana de Sousa, B.; de Araújo Neves, G.; Navarro de Lima Santana, L.; Rodrigues Menezes, R. A Review on Chitosan’s Uses as Biomaterial: Tissue Engineering, Drug Delivery Systems and Cancer Treatment. Materials 2020, 13, 4995. [Google Scholar] [CrossRef]
- Fleck, C.A.; Simman, R. Modern collagen wound dressings: Function and purpose. J. Am. Coll. Certif. Wound Spec. 2011, 2, 50–54. [Google Scholar] [CrossRef]
- Neamtu, B.; Barbu, A.; Negrea, M.O.; Berghea-Neamțu, C.Ș.; Popescu, D.; Zăhan, M.; Mireșan, V. Carrageenan-Based Compounds as Wound Healing Materials. Int. J. Mol. Sci. 2022, 23, 9117. [Google Scholar] [CrossRef] [PubMed]
- Mokhtari, H.; Tavakoli, S.; Safarpour, F.; Kharaziha, M.; Bakhsheshi-Rad, H.R.; Ramakrishna, S.; Berto, F. Recent Advances in Chemically-Modified and Hybrid Carrageenan-Based Platforms for Drug Delivery, Wound Healing, and Tissue Engineering. Polymers 2021, 13, 1744. [Google Scholar] [CrossRef]
- Mazurek, Ł.; Szudzik, M.; Rybka, M.; Konop, M. Silk Fibroin Biomaterials and Their Beneficial Role in Skin Wound Healing. Biomolecules 2022, 12, 1852. [Google Scholar] [CrossRef]
- Abazari, M.F.; Gholizadeh, S.; Karizi, S.Z.; Birgani, N.H.; Abazari, D.; Paknia, S.; Derakhshankhah, H.; Allahyari, Z.; Amini, S.M.; Hamidi, M.; et al. Recent Advances in Cellulose-Based Structures as the Wound-Healing Biomaterials: A Clinically Oriented Review. Appl. Sci. 2021, 11, 7769. [Google Scholar] [CrossRef]
- Weller, C.D.; Team, V.; Sussman, G. First-Line Interactive Wound Dressing Update: A Comprehensive Review of the Evidence. Front. Pharmacol. 2020, 11, 155. [Google Scholar] [CrossRef]
- Kim, D.S.; Seong, K.-Y.; Lee, H.; Kim, M.J.; An, S.-M.; Jeong, J.S.; Kim, S.Y.; Kang, H.-G.; Jang, S.; Hwang, D.-Y.; et al. Antiadhesive Hyaluronic Acid-Based Wound Dressings Promote Wound Healing by Preventing Re-Injury: An In Vivo Investigation. Biomedicines 2024, 12, 510. [Google Scholar] [CrossRef]
- Sulastri, E.; Zubair, M.S.; Lesmana, R.; Mohammed, A.F.A.; Wathoni, N. Development and Characterization of Ulvan Polysaccharides-Based Hydrogel Films for Potential Wound Dressing Applications. Drug Des. Devel. Ther. 2021, 15, 4213–4226. [Google Scholar] [CrossRef]
- Shen, S.; Chen, X.; Shen, Z.; Chen, H. Marine Polysaccharides for Wound Dressings Application: An Overview. Pharmaceutics 2021, 13, 1666. [Google Scholar] [CrossRef] [PubMed]
- Baghaie, S.; Khorasani, M.T.; Zarrabi, A.; Moshtaghian, J. Wound healing properties of PVA/starch/chitosan hydrogel membranes with nano Zinc oxide as antibacterial wound dressing material. Journal of Biomaterials Science. Polym. Ed. 2017, 28, 2220–2241. [Google Scholar] [CrossRef] [PubMed]
- Kamoun, E.A.; Kenawy, E.-R.S.; Chen, X. A review on polymeric hydrogel membranes for wound dressing applications: PVA-based hydrogel dressings. J. Adv. Res. 2017, 8, 217–233. [Google Scholar] [CrossRef] [PubMed]
- Lin, Y.-J.; Lee, G.-H.; Chou, C.-W.; Chen, Y.-P.; Wu, T.-H.; Lin, H.-R. Stimulation of wound healing by PU/hydrogel composites containing fibroblast growth factor-2. J. Mater. Chem. B 2015, 3, 1931–1941. [Google Scholar] [CrossRef] [PubMed]
- Morales-González, M.; Díaz, L.E.; Dominguez-Paz, C.; Valero, M.F. Insights into the Design of Polyurethane Dressings Suitable for the Stages of Skin Wound-Healing: A Systematic Review. Polymers 2022, 14, 2990. [Google Scholar] [CrossRef]
- Prete, S.; Dattilo, M.; Patitucci, F.; Pezzi, G.; Parisi, O.I.; Puoci, F. Natural and Synthetic Polymeric Biomaterials for Application in Wound Management. J. Funct. Biomater. 2023, 14, 455. [Google Scholar] [CrossRef] [PubMed]
- Muresan-Pop, M.; Magyari, K.; Vulpoi, A. PVA and PVP Hydrogel Blends for Wound Dressing: Synthesis and Characterisation. Adv. Mater. Res. 2019, 1151, 9–14. [Google Scholar] [CrossRef]
- De Lima, G.G.; de Lima, D.; de Oliveira, M.J.A.; LUGAO, A.; Alcântara, M.T.S.; Devine, D.M.; de Sá, M. Synthesis and in vivo behaviour of PVP/CMC/Agar hydrogel membranes impregnated with silver nanoparticles for wound healing applications. ACS Appl. Bio Mater. 2018, 1, 1842–1852. [Google Scholar] [CrossRef] [PubMed]
- Mir, M.; Ali, M.N.; Barakullah, A.; Gulzar, A.; Arshad, M.; Fatima, S.; Asad, M. Synthetic polymeric biomaterials for wound healing: A review. Prog. Biomater. 2018, 7, 1–21. [Google Scholar] [CrossRef] [PubMed]
- Xu, R.; Fang, Y.; Zhang, Z.; Cao, Y.; Yan, Y.; Gan, L.; Xu, J.; Zhou, G. Recent Advances in Biodegradable and Biocompatible Synthetic Polymers Used in Skin Wound Healing. Materials 2023, 16, 5459. [Google Scholar] [CrossRef]
- Visan, A.I.; Negut, I. Development and Applications of PLGA Hydrogels for Sustained Delivery of Therapeutic Agents. Gels 2024, 10, 497. [Google Scholar] [CrossRef] [PubMed]
- Wahlström, N.; Nylander, F.; Malmhäll-Bah, E.; Sjövold, K.; Edlund, U.; Westman, G.; Albers, E. Composition and structure of cell wall ulvans recovered from Ulva spp. along the Swedish west coast. Carbohydr. Polym. 2020, 233, 115852. [Google Scholar] [CrossRef] [PubMed]
- Zhang, Z.; Wang, F.; Wang, X.; Liu, X.; Hou, Y.; Zhang, Q. Extraction of the polysaccharides from five algae and their potential antioxidant activity in vitro. Carbohydr. Polym. 2010, 82, 118–121. [Google Scholar] [CrossRef]
- Robic, A.; Rondeau-Mouro, C.; Sassi, J.-F.; Lerat, Y.; Lahaye, M. Structure and interactions of ulvan in the cell wall of the marine green algae Ulva rotundata (Ulvales, Chlorophyceae). Carbohydr. Polym. 2009, 77, 206–216. [Google Scholar] [CrossRef]
- Ramu Ganesan, A.; Shanmugam, M.; Bhat, R. Producing novel edible films from semi refined carrageenan (SRC) and ulvan polysaccharides for potential food applications. Int. J. Biol. Macromol. 2018, 112, 1164–1170. [Google Scholar] [CrossRef]
- Thanh, T.T.; Quach, T.M.; Nguyen, T.N.; Vu Luong, D.; Bui, M.L.; Tran, T.T. Structure and cytotoxic activity of ulvan extracted from green seaweed Ulva lactuca. Int. J. Biol. Macromol. 2016, 93 Pt A, 695–702. [Google Scholar] [CrossRef]
- Tako, M.; Tamanaha, M.; Tamashiro, Y.; Uechi, S. Structure of Ulvan Isolated from the Edible Green Seaweed, Ulva pertusa. Adv. Biosci. Biotechnol. 2015, 6, 645–655. [Google Scholar] [CrossRef]
- Figueira, T.; da Silva, A.; Enrich-Prast, A.; Yoneshigue-Valentin, Y.; de Oliveira, V. Structural Characterization of Ulvan Polysaccharide from Cultivated and Collected Ulva fasciata (Chlorophyta). Adv. Biosci. Biotechnol. 2020, 11, 206–216. [Google Scholar] [CrossRef]
- Gajaria, T.K.; Lakshmi, D.S.; Vasu, V.T.; Reddy, C.R.K. Fabrication of ulvan-based ionically cross-linked 3D-biocomposite: Synthesis and characterization. Nanotechnol. Environ. Eng. 2022, 7, 455–459. [Google Scholar] [CrossRef]
- Ganji, F.; Vasheghani-Farahani, S.; Vasheghani-Farahani, E. Theoretical description of hydrogel swelling: A review. Iran. Polym. J. 2010, 19, 375–398. [Google Scholar]
- Zhang, M.; Zhao, X. Alginate hydrogel dressings for advanced wound management. Int. J. Biol. Macromol. 2020, 162, 1414–1428. [Google Scholar] [CrossRef] [PubMed]
- Smith, T.J.; Kennedy, J.E.; Higginbotham, C.L. The rheological and thermal characteristics of freeze-thawed hydrogels containing hydrogen peroxide for potential wound healing applications. J. Mech. Behav. Biomed. Mater. 2009, 2, 264–271. [Google Scholar] [CrossRef]
- Laia, A.G.S.; Costa Junior, E.S.; Costa, H.S. A study of sodium alginate and calcium chloride interaction through films for intervertebral disc regeneration uses. In Proceedings of the 21 CBECIMAT: Brazilian Congress of Engineering and Materials Science, Cuiabá, Brazil, 9–13 November 2014. [Google Scholar]
- Adelnia, H.; Ensandoost, R.; Moonshi, S.S.; Gavgani, J.N.; Vasafi, E.I.; Ta, H.T. Freeze/thawed polyvinyl alcohol hydrogels: Present, past and future. Eur. Polym. J. 2022, 164, 110974. [Google Scholar] [CrossRef]
- Jiang, X.; Xiang, N.; Zhang, H.; Sun, Y.; Lin, Z.; Hou, L. Preparation and characterization of poly(vinyl alcohol)/sodium alginate hydrogel with high toughness and electric conductivity. Carbohydr. Polym. 2018, 186, 377–383. [Google Scholar] [CrossRef]
- Ahmad, N. In Vitro and In Vivo Characterization Methods for Evaluation of Modern Wound Dressings. Pharmaceutics 2022, 15, 42. [Google Scholar] [CrossRef]
- Rahmati, M.; Mozafari, M. Protein adsorption on polymers. Mater. Today Commun. 2018, 17, 527–540. [Google Scholar] [CrossRef]
- Yoon, J.-Y.; Kim, J.-H.; Kim, W.-S. The relationship of interaction forces in the protein adsorption onto polymeric microspheres. Colloids Surf. A Physicochem. Eng. Asp. 1999, 153, 413–419. [Google Scholar] [CrossRef]
- Kodous, A.S.; Abdel-Maksoud, M.A.; El-Tayeb, M.A.; Al-Sherif, D.A.; Mohamed, S.S.A.; Ghobashy, M.M.; Emad, A.M.; Abd El-Halim, S.M.; Hagras, S.A.A.; Mani, S.; et al. Hesperidin—Loaded PVA/alginate hydrogel: Targeting NFκB/iNOS/COX-2/TNF-α inflammatory signaling pathway. Front. Immunol. 2024, 15, 1347420. [Google Scholar] [CrossRef] [PubMed]
- Hasan, M.M.; Islam, M.E.; Hossain, M.S.; Akter, M.; Rahman, M.A.A.; Kazi, M.; Khan, S.; Parvin, M.S. Unveiling the therapeutic potential: Evaluation of anti-inflammatory and antineoplastic activity of Magnolia champaca Linn’s stem bark isolate through molecular docking insights. Heliyon 2023, 10, e22972. [Google Scholar] [CrossRef] [PubMed]
- Lyu, S.; Untereker, D. Degradability of polymers for implantable biomedical devices. Int. J. Mol. Sci. 2009, 10, 4033–4065. [Google Scholar] [CrossRef] [PubMed]
- Kamoun, E.A.; Kenawy, E.-R.S.; Tamer, T.M.; El-Meligy, M.A.; Mohy Eldin, M.S. Poly(vinyl alcohol)-alginate physically crosslinked hydrogel membranes for wound dressing applications: Characterization and bio-evaluation. Arab. J. Chem. 2013, 8, 38–47. [Google Scholar] [CrossRef]
- Thai, V.L.; Ramos-Rodriguez, D.H.; Mesfin, M.; Leach, J.K. Hydrogel degradation promotes angiogenic and regenerative potential of cell spheroids for wound healing. Mater. Today Bio 2023, 22, 100769. [Google Scholar] [CrossRef] [PubMed]
- Suresh, S.K.; Bhat, S.; Guru, B.R.; Seetharam, R.N. A nanocomposite hydrogel delivery system for mesenchymal stromal cell secretome. Stem Cell Res. Ther. 2020, 11, 205. [Google Scholar] [CrossRef]
- Raina, N.; Pahwa, R.; Thakur, V.K.; Gupta, M. Polysaccharide-based hydrogels: New insights and futuristic prospects in wound healing. Int. J. Biol. Macromol. 2022, 223 Pt A, 1586–1603. [Google Scholar] [CrossRef]
- Caliari, S.R.; Burdick, J.A. A practical guide to hydrogels for cell culture. Nat. Methods 2016, 13, 405–414. [Google Scholar] [CrossRef]
- Quispe-Siccha, R.M.; Medina-Sandoval, O.I.; Estrada-Tinoco, A.; Pedroza-Pérez, J.A.; Martínez-Tovar, A.; Olarte-Carrillo, I.; Cerón-Maldonado, R.; Reding-Bernal, A.; López-Alvarenga, J.C. Development of Polyvinyl Alcohol Hydrogels for Controlled Glucose Release in Biomedical Applications. Gels 2024, 10, 668. [Google Scholar] [CrossRef]
- Keykhaee, M.; Sorouri, F.; Rahimifard, M.; Baeeri, M.; Forumadi, A.; Firoozpour, L.; Khoobi, M. Polysaccharide-based hydrogel enriched by epidermal growth factor peptide fragment for improving the wound healing process. Heliyon 2023, 9, 2405–8440. [Google Scholar] [CrossRef] [PubMed]
- Liu, T.; Wang, Y.; Kuang, T. Oriented Porous Polymer Scaffolds in Tissue Engineering: A Comprehensive Review of Preparation Strategies and Applications. Macromol. Mater. Eng. 2023, 309, 2300246. [Google Scholar] [CrossRef]
- Yazdi, M.K.; Vatanpour, V.; Taghizadeh, A.; Taghizadeh, M.; Ganjali, M.R.; Munir, M.T.; Habibzadeh, S.; Saeb, M.R.; Ghaedi, M. Hydrogel membranes: A review. Mater. Sci. Engineering. C Mater. Biol. Appl. 2020, 114, 111023. [Google Scholar] [CrossRef] [PubMed]
- Op ’t Veld, R.C.; Walboomers, X.F.; Jansen, J.A.; Wagener, F.A.D.T.G. Design Considerations for Hydrogel Wound Dressings: Strategic and Molecular Advances. Tissue Engineering. Part B Rev. 2020, 26, 230–248. [Google Scholar] [CrossRef] [PubMed]
- Maray, S.O.; Abdel-Kareem, M.S.M.; Mabrouk, M.E.M.; El-Halmouch, Y.; Makhlof, M.E.M. In Vitro Assessment of Antiviral, Antimicrobial, Antioxidant and Anticancer Activities of Ulvan Extracted from the Green Seaweed Ulva lactuca. Thalassas 2023, 39, 779–790. [Google Scholar] [CrossRef]
- Ibrahim, M.I.A.; Amer, M.S.; Ibrahim, H.A.H.; Zaghloul, E.H. Considerable Production of Ulvan from Ulva lactuca with Special Emphasis on Its Antimicrobial and Anti-fouling Properties. Appl. Biochem. Biotechnol. 2022, 194, 3097–3118. [Google Scholar] [CrossRef]
- Podolean, I.; Coman, S.M.; Bucur, C.; Teodorescu, C.; Kikionis, S.; Ioannou, E.; Roussis, V.; Primo, A.; Garcia, H.; Parvulescu, V.I. Catalytic transformation of the marine polysaccharide ulvan into rare sugars, tartaric and succinic acids. Catal. Today 2020, 383, 345–357. [Google Scholar] [CrossRef]
- Sundberg, A.; Sundberg, K.; Lillandt, C.; Holmbom, B. Determination of hemicelluloses and pectins in wood and pulp fibres by acid methanolysis and gas chromatography. Nord. Pulp Pap. Res. J. 1996, 11, 216–219. [Google Scholar] [CrossRef]
- Stan, D.; Codrici, E.; Enciu, A.-M.; Olewnik-Kruszkowska, E.; Gavril, G.; Ruta, L.L.; Moldovan, C.; Brincoveanu, O.; Bocancia-Mateescu, L.-A.; Mirica, A.-C.; et al. Exploring the Impact of Alginate—PVA Ratio and the Addition of Bioactive Substances on the Performance of Hybrid Hydrogel Membranes as Potential Wound Dressings. Gels 2023, 9, 476. [Google Scholar] [CrossRef]
- Stauffer, S.R.; Peppast, N.A. Poly(vinyl alcohol) hydrogels prepared by freezing-thawing cyclic processing. Polymer 1992, 33, 3932–3936. [Google Scholar] [CrossRef]
- Arafa, A.A.; Nada, A.A.; Ibrahim, A.Y.; Zahran, M.K.; Hakeim, O.A. Greener Therapeutic pH-Sensing Wound Dressing Based on Curcuma Longa and Cellulose Hydrogel. Eur. Polym. J. 2021, 159, 110744. [Google Scholar] [CrossRef]
- Yang, S.; Wu, Z.-H.; Yang, W.; Yang, M.-B. Thermal and mechanical properties of chemical crosslinked polylactide (PLA). Polym. Test. 2008, 27, 957–963. [Google Scholar] [CrossRef]
- Fuoco, T.; Cuartero, M.; Parrilla, M.; García-Guzmán, J.J.; Crespo, G.A.; Finne-Wistrand, A. Capturing the Real-Time Hydrolytic Degradation of a Library of Biomedical Polymers by Combining Traditional Assessment and Electrochemical Sensors. Biomacromolecules 2021, 22, 949–960. [Google Scholar] [CrossRef]
- Stefan, L.M.; Iosageanu, A.; Ilie, D.; Stanciuc, A.M.; Matei, C.; Berger, D.; Craciunescu, O. Extracellular matrix biomimetic polymeric membranes enriched with silver nanoparticles for wound healing. Biomed. Mater. 2021, 16, 3. [Google Scholar] [CrossRef] [PubMed]

| Material | Composition | Advantages | Disadvantages | Ref. | |
|---|---|---|---|---|---|
| Natural polymers | Chitin | Semicrystalline polysaccharide made up of monomeric units of—(1→4)-2-amino-2-deoxy-d-glucose and—(1→4)-2-acetamide-2-deoxy-d-glucose. | Gel-forming Biodegradable Non-toxic Antimicrobial properties | Weak mechanical properties Poor solubility in aqueous solutions | [22,23] |
| Chitosan | Co-polymers N-acetyl-d-glucose amine and d-glucose amine | Gel-forming Biodegradable Non-toxic Antimicrobial properties Surface-induced thrombosis, platelet activation, and blood clotting Cytokine release | Solubilization in acetic acid solution, toxic for mammalian cells Hydrogels made from chitosan and crosslinking agents have less antimicrobial effect due to poor solubility Properties vary depending on origin, extraction method, and molecular weight. | [24] | |
| Collagen | Amino acids proline, glycine and hydroxyproline | Anti-inflammatory Antifibrotic Analgesic properties Promotes angiogenesis | Denaturation in the manufacturing process can determine loss of therapeutic effect Lack of antimicrobial effect Weak mechanical properties | [25] | |
| Carrageenan | Sulphated polysaccharide composed of alternative units of 3-linked b-d-galactopyranose (G-units) and 4-linked a-d-galactopyranose (d-units) | Good viscoelastic properties Water soluble Low cytotoxicity Antimicrobial and antioxidant properties Does not stick to the wound | Low mechanical strength Difficult reproducibility because the gel network is influenced by many factors (ions, molecular weight, monosaccharide content, pH, and temperature Can have side effects on blood, clothing, and immune system | [26,27] | |
| Silk fibroin | Fibrous protein with a semi-crystalline structure, with a heavy and a light chain, linked through a disulfide bound | Highly biocompatible and biodegradable Increase expression of NF-kB signaling pathway, which influences cell proliferation and adhesion, as well as inflammation Determines expression of fibronectin, type III collagen, MMP-12, and integrin β1 in burn-induced rat wounds | No antimicrobial effect Bacterial biofilms can form on the surface of silk fibers | [28] | |
| Cellulose | Organic polysaccharide, composed of d-glucose bound by 1-4-β-glycosidic linkages | Can be obtained from various sources (bacteria, tunicates, and plants) Has tunable physico-chemical, mechanical, and biological properties Is biocompatible and biodegradable | Cannot be used in its native form because it is rich in hydroxyl groups Lack of antibacterial effect | [29] | |
| Alginate | Composed of β-d-mannuronate (M) and α-l-guluronate residues, linked by 1,4 glycosidic bonds | Adsorbent properties Can form a gel with wound exudate Can keep a moist environment Hemostatic effect Can be easily remove, without inducing further trauma | Their lack of adhesive properties triggers the need for a second dressing Can trigger allergic reactions | [30] | |
| Hyaluronic acid | High molecular weight polysaccharide, composed of d-glucuronic acid and N-acetyl glucosamine | High biocompatibility No immunogenicity Stimulates cell migration, proliferation, and differentiation Regulates the expression of extracellular matrix proteins Contributes to the removal of dead tissue Induces secretion of inflammatory cytokines Regulates the re-epithelization process by interacting with keratinocyte CD44 receptors | Low mechanical stability Easily adheres to skin and can cause additional damage when removed Needs to be modified to be suitable for wound dressing | [31] | |
| Ulvan | Sulfated polysaccharide, consisting of glucuronic acid and/or iduronic acid coupled with sugars such as rhamnose, xylose, arabinose and glucose | Water soluble Antioxidant and antimicrobial activity Immunomodulatory action Improved swelling rate Rhamnose-rich polysaccharides can trigger cell proliferation and collagen synthesis Only algal polysaccharide that contains iduronic acid, which has similar structure to mammalian glycosaminoglycans (GAG) Utilizing algal compounds can contribute to the global problem of nuisance macroalgal blooms | High variability in composition due to algal habitat, season of collection, and extraction methods, which can induce modified bioactivity. Poor mechanical strength. | [32,33] | |
| Synthetic polymers | Polyvinyl alcohol (PVA) | PVA is obtained through the hydrolysis or alcoholysis of polyvinyl acetate (PVAc). The process typically involves base-catalyzed hydrolysis in the presence of methanol or ethanol. | Non-carcinogenic nature, bio-adhesive properties, non-toxicity, and exceptional film-forming ability and transparency, as well as a high swelling capacity in water or biological fluids | PVA hydrogel has inadequate elasticity | [34,35] |
| Polyurethane (PU) | PU is obtained by the condensation polymerisation of an isocyanate (R′-(N=C=O)n) and a polyol (R-(OH)n). The most commonly used isocyanates are the aromatic diisocyanates toluene diisocyanate (TDI) and methylene diphenyl diisocyanate (MDI) and the most commonly used polyols are hydroxyl-terminated polyethers or polyesters. | High biocompatibility, high mechanical strength and flexibility, easy processability, possibility to modify the surface functional properties | PU has hydrophobic properties; the hydrophilicity must be improved. PU has no antibacterial properties and may be toxic due to the obtaining process by using petroleum-based raw material. | [36,37] | |
| Polyvinylpyrrolidone (PVP) | PVP is a nonionic polymer compound produced by the polymerization of N-vinylpyrrolidone (NVP). | Biodegradable, water soluble, biocompatible, antibacterial mechanism. PVP has the capacity to encapsulate and release antibiotics. | Hydrogel blends with higher PVP concentrations exhibit increased fragility and rapid dissolution in water, which can limit their stability and effectiveness in long-term applications. PVP has inferior mechanical properties and limited swelling capability. | [38,39,40] | |
| Polycaprolactone (PCL) | PCL is a polyester that can be obtained by two methods: (a) ring opening polymerization of ε-caprolactone by using stannous chloride or (b) polycondensation of 6-hydroxyhexanoic acid (C6H12O3). | Biocompatibility, biodegradability, bioresorbable, FDA approved, and has slower degradation rate. Electrospun PCL fibers are well-suited for the treatment of both acute and chronic wounds. | PCL has limited antimicrobial activity, and its highly hydrophobic nature provides fewer binding sites for cell adhesion, migration, and proliferation. | [41,42] | |
| Poly(lactide-co-glycolide) (PLGA) | PLGA is obtained by ring-opening co-polymerization of lactic acid (LA) and glycolic acid (GA). During polymerization, monomeric units of LA and GA are sequentially connected in PLGA through ester linkages, resulting in the formation of a linear, aliphatic polyester. | Good mechanical strength, biocompatible, biodegradable, FDA approved. PLGA is used in the preparation of skin substitutes. PLGA hydrogels are used for controlled delivery of various therapeutic agents. | PLGA-based scaffolds are hydrophobic and semi-permeable, which restricts their ability to absorb exudates. The degradation of PLGA into its monomers can lead to their accumulation in the body, potentially causing localized pH fluctuations and inflammation. Excessive acidity from PLGA degradation can trigger apoptosis or necrosis, damaging surrounding tissues. | [41,42,43] | |
| Chemical Element | Percentage (g/%) |
|---|---|
| Carbon | 25.9 |
| Hydrogen | 5.0 |
| Nitrogen | 3.3 |
| Sulfur | 4.2 |
| Monomers | Proportion (%) |
|---|---|
| Rhamnose | 48.7 |
| Glucuronolactone | 24.8 |
| Glucose | 11.3 |
| Xylose | 4 |
| Ribose | 3.5 |
| Galactose | 2.38 |
| Mannose | 1 |
| Sample | pH Value (n = 3) | Average | STDEV | CV |
|---|---|---|---|---|
| Base (Alg + PVA) | 6.59 | 6.66 | 0.06 | 0.92 |
| 6.71 | ||||
| 6.67 | ||||
| 0.1 ULV | 6.89 | 6.73 | 0.23 | 3.38 |
| 6.83 | ||||
| 6.47 | ||||
| 0.5 ULV | 6.89 | 6.94 | 0.07 | 0.98 |
| 6.92 | ||||
| 7.02 | ||||
| 1 ULV | 7.15 | 6.72 | 0.63 | 9.37 |
| 7.02 | ||||
| 6.00 |
| Sample | G′ (Pa) | G″ (Pa) | Yield Stress (Pa) |
|---|---|---|---|
| Alg + PVA | 7071 | 621.8 | 1584 |
| Alg + PVA + 0.1 ULV | 8818 | 773.2 | 1294 |
| Alg + PVA + 0.5 ULV | 9322 | 717.1 | 631.2 |
| Alg + PVA + 1.0 ULV | 16,050 | 1583 | 2049 |
| Sample | Min–Max (µm) | FWHM (µm) Full Width at Half Maximum | Mean ± SD (µm) |
|---|---|---|---|
| Alg PVA | 3–120 | 12–51 | 30.8 ± 21.0 |
| 0.1 ULV | 7–112 | 15–50 | 32.5 ± 17.8 |
| 0.5 ULV | 16–131 | 29–66 | 48.1 ± 19.3 |
| 1 ULV | 20–186 | 35–90 | 64.2 ± 29.1 |
| Sample/Control | BSA Solution Quantity | Gel/Water Quantity | PBS Quantity |
|---|---|---|---|
| Positive control (aspirin) | 900 µL | 200 µL aspirin solution | 2800 µL |
| Negative control | 900 µL | 200 µL water | 2800 µL |
| Hydrogel membrane samples | 900 µL | 200 mg | 2800 µL |
Disclaimer/Publisher’s Note: The statements, opinions and data contained in all publications are solely those of the individual author(s) and contributor(s) and not of MDPI and/or the editor(s). MDPI and/or the editor(s) disclaim responsibility for any injury to people or property resulting from any ideas, methods, instructions or products referred to in the content. |
© 2024 by the authors. Licensee MDPI, Basel, Switzerland. This article is an open access article distributed under the terms and conditions of the Creative Commons Attribution (CC BY) license (https://creativecommons.org/licenses/by/4.0/).
Share and Cite
Stan, D.; Mirica, A.-C.; Mocanu, S.; Stan, D.; Podolean, I.; Candu, N.; El Fergani, M.; Stefan, L.M.; Seciu-Grama, A.-M.; Aricov, L.; et al. Hybrid Hydrogel Supplemented with Algal Polysaccharide for Potential Use in Biomedical Applications. Gels 2025, 11, 17. https://doi.org/10.3390/gels11010017
Stan D, Mirica A-C, Mocanu S, Stan D, Podolean I, Candu N, El Fergani M, Stefan LM, Seciu-Grama A-M, Aricov L, et al. Hybrid Hydrogel Supplemented with Algal Polysaccharide for Potential Use in Biomedical Applications. Gels. 2025; 11(1):17. https://doi.org/10.3390/gels11010017
Chicago/Turabian StyleStan, Dana, Andreea-Cristina Mirica, Sorin Mocanu, Diana Stan, Iunia Podolean, Natalia Candu, Magdi El Fergani, Laura Mihaela Stefan, Ana-Maria Seciu-Grama, Ludmila Aricov, and et al. 2025. "Hybrid Hydrogel Supplemented with Algal Polysaccharide for Potential Use in Biomedical Applications" Gels 11, no. 1: 17. https://doi.org/10.3390/gels11010017
APA StyleStan, D., Mirica, A.-C., Mocanu, S., Stan, D., Podolean, I., Candu, N., El Fergani, M., Stefan, L. M., Seciu-Grama, A.-M., Aricov, L., Brincoveanu, O., Moldovan, C., Bocancia-Mateescu, L.-A., & Coman, S. M. (2025). Hybrid Hydrogel Supplemented with Algal Polysaccharide for Potential Use in Biomedical Applications. Gels, 11(1), 17. https://doi.org/10.3390/gels11010017

